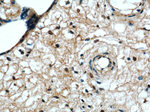
EDRF1 Antibody in Immunohistochemistry (Paraffin) (IHC (P))
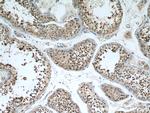
EDRF1 Antibody in Immunohistochemistry (Paraffin) (IHC (P))

Search
Proteintech
EDRF1 Polyclonal Antibody
{{$productOrderCtrl.translations['antibody.pdp.commerceCard.promotion.promotions']}}
{{$productOrderCtrl.translations['antibody.pdp.commerceCard.promotion.viewpromo']}}
{{$productOrderCtrl.translations['antibody.pdp.commerceCard.promotion.promocode']}}: {{promo.promoCode}} {{promo.promoTitle}} {{promo.promoDescription}}. {{$productOrderCtrl.translations['antibody.pdp.commerceCard.promotion.learnmore']}}
产品信息
21883-1-AP
种属反应
宿主/亚型
分类
类型
抗原
偶联物
形式
浓度
规格
纯化类型
保存液
内含物
保存条件
运输条件
产品详细信息
Immunogen sequence: NFESIEDAT NAALLLCNTG RLMRICAQAH CGAGDELKRE FSPEEGLYYN KAIDYYLKAL RSLGTRDIHP AVWDSVNWEL STTYFTMATL QQDYAPLSRK AQEQIEKEVS EAMMKSLKYC DVDSVSARQP LCQYRAATIH HRLASMYHSC LRNQVGDEHL RKQHRVLADL HYSKAAKLFQ LLKDAPCELL RVQLERVAFA EFQMTSQNSN VGKLKTLSGA LDIMVRTEHA FQLIQKELIE EFGQPKSGDA AAAADASPSL NREEVMKLLS IFESRLSFLL LQSIKLLSST KKKTSNNIED DTILKTNKHI YSQLLRATAN KTATLLERIN VIVHLLGQLA AGSAASSNAV Q (889-1238 aa encoded by BC107479)
靶标信息
This gene may play a role in erythroid cell differentiation. The encoded protein inhibits DNA binding of the erythroid transcription factor GATA-1 and may regulate the expression of alpha-globin and gamma-globin. Alternative splicing results in multiple transcript variants.
仅用于科研。不用于诊断过程。未经明确授权不得转售。
篇参考文献 (0)
生物信息学
蛋白别名: EDRF1; Erythroid differentiation-related factor 1; unnamed protein product
基因别名: 2700050L05Rik; AU022667; AW558805; C10orf137; EDRF1; RGD1306820
UniProt ID: (Human) Q3B7T1, (Mouse) Q6GQV7
Entrez Gene ID: (Human) 26098, (Rat) 309069, (Mouse) 214764